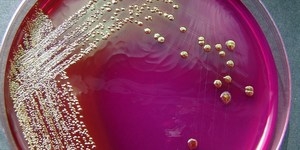

Кишечная палочка во влагалище, симптомы которой хорошо изучены, согласно статистическим данным, вызывает цистит у большинства женщин. Она же становится причиной возникновения пиелонефрита, поражающего беременных женщин.
Воспаление женских мочеполовых органов, вызванное кишечной бактерией, обычно лечится долго и часто приобретает хроническую форму. Эти болезни трудно поддаются лечению.
Иногда в организме начинается воспалительный процесс, протекающий без четко выраженных симптомов. Женщина не чувствует никакого дискомфорта и считает, что она абсолютно здорова, хотя в организме у нее хроническая инфекция.
Когда течение инфекции не имеет ярко выраженного характера, то воспаление может быстро перейти в активную форму. Для этого достаточно любого небольшого воздействия:
- переохлаждения;
- стресса;
- скандала.
Все это приводит к снижению защитных ресурсов организма, его иммунная система теряет возможность сопротивляться болезни. Именно поэтому у женщин – носительниц кишечной бактерии возникают самые разные хронические заболевания: кольпит, пиелонефрит, цистит, эндометрит.
Обострение этих заболеваний происходит даже при обычной простуде. Лечиться можно долгие годы, но достигнуть положительного результата, даже при современной терапии, очень сложно.
Как кишечная палочка попадает в уретру?
До 80% заболеваний мочеполовой системы вызываются именно кишечной палочкой. Это простатиты, уретриты, циститы, пиелонефриты, орхоэпидидимиты. И попадает она в эти органы почти всегда восходящим путем, то есть из мочеиспускательного канала.
В уретру же E.Coli попадает контактным путем из окружающей среды:
- из анального канала при несоблюдении должной гигиены (см. );
- при анальном сексе;
- реже — из других источников (например, купание в открытых водоемах).
У женщин кишечная палочка в мазках из цервикального канала и уретры встречается чаще, но и у здоровых мужчин она выявляется в 25-30% случаев.
Инфицированность E.Coli не относится к инфекциям, передающимся половым путем. Нужно ли эту инфекцию лечить?
Однако, если жжение и болезненность в половом члене продолжает напоминать о себе несколько дней, а к этим явлениям добавились еще и похожие на гнойные выделения – поход к врачу неминуем. Но если все прошло благополучно, то, может быть, мужчин успокоит тот факт, что в их мазке, взятом из уретры, все выглядит намного проще, если, конечно, анализ нормальный:
- Норма лейкоцитов – до 5 клеток в поле зрения;
- Флору составляют единичные палочки;
- Общий фон разбавляет эпителий уретры (в основном, переходный) – приблизительно 5-7 (до 10) клеток;
- Небольшое количество слизи, не играющее никакой роли;
- Иной раз в мазке может присутствовать условно-патогенная флора в единичных экземплярах (стрептококки, стафилококки, энтерококки), однако чтобы ее дифференцировать, необходимо покрасить мазок по Граму.
В случае воспалительного процесса мазок меняется:
- Появляется большое количество лейкоцитов в мазке, иногда не подлежащее подсчету;
- Кокковая или кокко-бациллярная флора вытесняет палочковую;
- В препарате присутствуют микробы, вызвавшие воспаление (трихомонады, гонококки, дрожжи и др.);
- Микроорганизмы типа хламидий, уреа- и микоплазм под микроскопом вряд ли возможно увидеть, точно так же, как и отличить патогенные диплококки, вызывающие гонорею, от попарно лежащих энтерококков или цепочки Enterococcus faecalis (энтерококки тоже) от стрептококков, поэтому в таких случаях для уточнения вида возбудителя исследование дополняют культуральным методом или практически универсальной и популярной в наше время ПЦР (полимеразная цепная реакция);
- За редким исключением в мужском мазке можно обнаружить кишечную палочку (вопиющее нарушение гигиенических правил!), приносящую пользу в кишечнике, но вызывающую циститы, уретриты, простатиты, попадая в мочеиспускательный канал мужчины. Для ее дифференцировки также необходимы дополнительные лабораторные методы исследования.
Аналогично поступают и с женскими мазками, поскольку найденные диплококки могут оказаться отнюдь не нейссериями и гонорею не вызывать. Кстати, кишечную палочку (Escherichia coli), энтерококк (Enterococcus faecalis), стафилококки со стрептококками и другие микроорганизмы в женских мазках встречаются значительно чаще, что обусловлено строением женских половых органов.
Симптомы и диагностика кишечной палочки в организме
При кишечном дисбактериозе наблюдаются разные симптомы. Они похожи у женщин, мужчин и детей, поэтому определить их не сложно. Наблюдается запор, понос, тошнота, вздутие, боли в животе, рвота. У больных каловые массы меняют свой запах на неприятный, что происходит и в ротовой полости. Появляется быстрая утомляемость, слабость, сонливость или наоборот бессонница, отсутствует аппетит.
При лечении кишечной инфекции больным приписывают щадящую диету:
- водянистые супы;
- каши на воде;
- черствый белый хлеб;
- сухарики;
- отварные овощи;
- отварная нежирная рыба и мясо.
При рвоте или поносе больному дают регидратационный раствор по 400 мл на каждый момент рвоты или поноса. Рассмотрите подробнее каждый антибиотик:
- Препарат Имипенем хорошо справляется с вредоносными бактериями. Плюсом данного средства является его стоимость и удобство использования (в виде инъекций). Минусом является возможная аллергия пациента на пенициллины или другие вещества средства, его не приписывают. Его нельзя принимать детям до 3-х месяцев, во время лактации или детям с почечной недостаточностью. Препарат отпускается только по рецепту лечащего врача.
- Офлоксацин – это эффективное средство при борьбе с палочками. Плюсом такого препарата является оральное использование (таблетки или капсулы), невысокая цена. Минус – нельзя применять при эпилепсии, после инсульта или воспаления центральной нервной системы, детям до 18 лет, при беременности, аллергии на компоненты или в период лактации. Его можно купить только по рецепту.
После выздоровления принимают приблизительно 2 недели энтерособренты, пробиотики:
- Полифепан является природным сорбентом, который поглощает все возможные токсические палочки. Плюс – можно купить без рецепта по низкой стоимости. Минус – нельзя принимать при запорах, гастрите, сахарном диабете или аллергии на главное или вспомогательные вещества.
- Энтерол является пробиотиком, который способствует нормализации микрофлоры кишечника, является антидиарейным средством. Плюс – можно купить по низкой стоимости, без рецепта от лечащего врача. Минус – его нельзя принимать с аллергией на главный или вспомогательные компоненты препарата, или пациентам с установленным центральным венозным катетером.
- боли и рези при мочеиспускании;
- не наблюдаемые ранее ;
- покраснение наружного отверстия мочеиспускательного канала;
- высыпания на половом члене;
- боли при половом акте.
Естественное желание мужчины – это исключить ЗППП. Всем мужчинам, обратившимся к урологу, андрологу или венерологу, назначается на наличие воспалительных изменений и микробной флоры. Узкий стерильный тампон вводится на 2-3 см внутрь уретры, затем полученный материал наносится на предметное стекло, высушивается и отправляется в лабораторию. Там его окрашивают и рассматривают под обычным микроскопом.
Мазок также может назначаться и при отсутствии жалоб:
- При выявлении вагинита у половой партнерши.
- При обследовании пары по поводу бездетности.
- Перед урологическими операциями или манипуляциями.
Что может увидеть лаборант:
- лейкоциты (в норме их должно быть не более 5 в поле зрения);
- эритроциты (не более 2-3);
- клетки эпителия (не более 10);
- слизь (умеренное количество);
- кокки или кишечная палочка (в норме — единичные в препарате);
- грибки;
- гонококки (см. );
Если воспалительные изменения есть (большое количество лейкоцитов, эритроцитов, клеток эпителия, слизи), а гонококки и трихомонады не выявляются, назначаются для выявления хламидиоза, микоплазмоза, генитального герпеса, а также посев уретральных выделений на питательные среды.
Если при обследовании случайно выявлена кишечная палочка, но мужчину ничего не беспокоит, нет воспалительных изменений в мазке – лечить такое носительство не надо. При отсутствии жалоб следует назначать лечение только перед хирургическими манипуляциями на мочеполовых органах.
Но, даже если у мужчины выявлены признаки воспалительного процесса, это вовсе не означает, что он вызван обнаруженной Е.Coli. Она зачастую может сопутствовать другим инфекциям. Поэтому мужчины при различных воспалительных процессах в урогенитальном тракте всегда должны обследоваться на все инфекции, передающиеся половым путем.
Лечение партнерши показано только при наличии у нее клинических признаков воспаления.
Кроме того, под прикрытием кишечной палочки могут прятаться другие инфекции, которые не выявляются с помощью микроскопии. Если их вовремя не обнаружить, можно упустить время лечением, которое для таких инфекций неэффективно.
Правильный план обследования и лечения может назначить только специалист.
Кишечная палочка у мужчин живёт в прямой кишке, возле выхода из анального отверстия. При несоблюдении гигиены она легко может попасть в другие органы.
Данная бактерия приносит пользу, если находится в достаточном количестве, чтоб принимать участие в синтезе витаминов.
- Частое, болезненное мочеиспускание (симптомы цистита – воспаления мочевого пузыря).
- Обильные выделения из влагалища . Выделения могут быть белыми, желтоватыми . Это симптомы вагинита (кольпита) – воспаления влагалища.
- Болевые ощущения во время сексуальных контактов, потеря сексуального влечения.
- Вялость, слабость, головная боль, повышение температуры (симптомы интоксикации).
Выявить наличие кишечной палочки в простом мазке на микрофлору практически невозможно. О развитии воспалительного процесса расскажет высокое содержание лейкоцитов в результате анализа.
Поэтому при высоком уровне лейкоцитов всегда назначают бакпосев, который и покажет кишечную палочку. Одновременно с выявлением возбудителя будет проведён и анализ чувствительности к антибиотикам (это понадобится для назначения максимально эффективного лечения).
В случаях обнаружения в посеве мазка кишечных палочек до 104КОЕ/мл и хорошей микрофлоре влагалища , лечение проводить не обязательно. Но если микрофлора слабая, либо показатели превышают норму, то необходимо провести курс лечения.
- Следует отказаться от жирных, жареных, солёных, копчёных продуктов.
- Любая выпечка из дрожжевого теста так же попадает под запрет.
- Квашеные продукты (капуста, огурцы) следует временно исключить из рациона.
- Пиво, вино и другой алкоголь употреблять во время лечения запрещено.
- Разрешено употреблять варёную еду и блюда, приготовленные на пару. Мясо использовать не жирное.
- В рацион необходимо ввести йогурты (натуральные) и биокефир. Это поможет в восстановлении нормальной микрофлоры кишечника (а значит и улучшит иммунитет).
Если общее состояние не сильно нарушено, то лечение проводят в амбулаторных условиях. По окончании цикла лечения необходимо сдать повторные анализы.
При обнаружении в мазке кишечной палочки необходимо начать незамедлительное лечение. Чем лечиться и каким образом, расскажет врач. Если болезнь запустить, потребуется очень сложное лечение, после которого организм будет долго восстанавливаться.
Какие использовать свечи, по какой схеме их нужно применять, как долго придется лечиться, – все это устанавливает только лечащий врач. Он проводит диагностику заболевания, ставит точный диагноз и рассказывает, чем лучше всего начать лечение.
Если у беременной обнаружили кишечную инфекцию, ее немедленно кладут в стационар. Вредный микроорганизм может отрицательно повлиять на плод. В это время женщина не может принимать много медицинских препаратов. Беременным женщинам назначается местная терапия, а также не очень сильные лекарства.
Кишечная палочка, найденная у мужчин, также лечится антибиотиками, назначается прием бактериофага. Многие пытаются проводить такое лечение самостоятельно. Однако следует напомнить, что бессистемный прием антибиотиков может привести к негативным последствиям, а положительной динамики так и не будет.
Кроме медикаментозной терапии, исследования желудочно-кишечного тракта, врачами назначаются специальные процедуры:
- подмывание травяными отварами;
- ультрафиолетовое облучение.
Чтобы кишечная палочка не проникла в ваш организм, всегда соблюдайте гигиену.
Женщины должны делать лечебное спринцевание и принимать специальные лекарства, восстанавливающие микрофлору. Для укрепления иммунитета и женщинам, и мужчинам назначается прием витаминов.
Лечение кишечной инфекции требует соблюдение определенной диеты. Из постоянного рациона необходимо исключить соленое, жареное, копченое, острое, сладкое.
Разрешается питаться только вареными овощами, разными фруктами. Причем овощи необходимо предварительно хорошо измельчить. После окончания лечения нужно обязательно сделать контрольные анализы.
Фактически, некоторые исследования показали, что противомикробные препараты могут увеличить шансы на развитие инфекции мочевыводящих путей (до 17 раз). Считается, что это происходит потому, что антибиотик повреждает бактерии, вызывая высвобождение еще большего количества токсина из них.
Большинство исследователей рекомендуют использовать противомикробные средства только в том случае, если пациент является септическим, то есть имеются доказательства того, что инфекция распространилась за пределы кишечника.
Назначение атропина, дифеноксилата и других препаратов, которые обычно используются для борьбы с диареей, также может усиливать симптомы заболевания и вызывать осложнения.
Таким образом, некоторые малоопасные инфекции лечатся следующим образом:
- отдых;
- адекватное восполнение жидкости;
- редко, антибиотики.
Чем лечить тяжелые симптомы инфекции и осложнения:
- лечение в отделении интенсивной терапии;
- внутривенные жидкости и электролиты;
- переливание плазмы, тромбоцитов и эритроцитов;
- диализ почек;
- лекарства для повышения кровяного давления;
- медикаменты для подавления судорог;
- трансплантация почки.
Заключение
Чтобы кишечная палочка не проникла в ваш организм, всегда соблюдайте гигиену. Носите только чистую и удобную одежду, Постоянно мойте руки и не прикасайтесь к грязным предметам и растениям.
В мазке у женщины обнаружены кишечные палочки – что предпринять в данной ситуации, в чем заключаются причины и лечение этого состояния, что делать если инфекция обнаружена у беременной и как вылечить это не навредив плоду? Обо всем подробно и доступно в нашей статье.
Что это такое
Данный микроорганизм был выделен еще в 1885 году. Сегодня же известны многие его разновидности. Из них масса является безвредной и необходимой составляющей микрофлоры кишечника. Кишечная палочка принимает участие в синтезе ряда витаминов, таких как К, группы В.
Но существует больше ста видов микроорганизма, являющиеся патогенными и способные спровоцировать серьезные заболевания или отравления.
Даже бактерии, которые относятся к условно-патогенным, попадая из кишечника в другие органы, могут представлять опасность.
Нормальная среда обитания палочки – расположенный ближе к анальному отверстию участок толстой кишки.
Считается, что в малых количествах эта бактерия вполне может присутствовать во влагалище, но при ее размножении она приводит к проблемам, таким как бактериальный вагиноз и многие другие.
Методы выявления
Большинство женщин хоть раз в год пытаются проходить обследование в женской консультации. Осматривая половые органы, гинеколог делает забор материала, известный как мазок, для чего используется специальное стеклышко. Затем этот материал отправляется в лабораторию, где проводится его подробное исследование.
Во влагалище обитает масса частиц, составляющих микрофлору. Они защищают женщину от попадания в этот участок инфекционных частиц.
Исследование мазка дает возможность определить, насколько здорова местная микрофлора. Именно анализ посредством микроскопа и химических реакций дает возможность выявить наличие во взятом материале кишечной палочки.
Причины появления
Существует несколько основных причин, по которым данный микроорганизм может попасть во влагалище:
-
Ненадлежащая гигиена, а конкретнее, неправильное подмывание. Влагалище и анальное отверстие находятся рядом, потому подмываться нужно не снизу вверх, а сверху вниз, чтобы предупредить занесение патогенных микробов.
-
Неправильное нижнее белье. Также микроорганизмы могут попасть во влагалище из-за ношения тесного белья и стрингов.
Последние нравятся многим женщинам, ведь это красиво и сексуально, но все же лучше не злоупотреблять ими, выбирая здоровье, а не красоту.
Стоит выбирать нижнее белье из качественных натуральных материалов.
-
Незащищенный секс. Получить кишечную палочку можно при совмещенном, то есть, анально-вагинальном контакте.
Поэтому любителям разнообразия в постели нужно внимательно относиться к средствам защиты.
Также повышает риск попадания в мазок палочки постоянная смена половых партнеров, ослабленный иммунитет и частые спринцевания.
Симптомы обычно исчезают сами за пару дней. Причина этого в самопроизвольной санации кишечника. Но если такое состояние не проходит более двух дней, обращайтесь к врачу.
Если во влагалищном мазке была выявлена кишечная палочка, это серьезный повод как можно раньше начать лечение. Правильно расписать его тактику, конечно, может только врач. В основном используются антибактериальные препараты.
Какие препараты назначают
Иногда достаточно местной терапии, но при достаточно серьезном характере поражения требуется более основательное лечение. Антибактериальная коррекция проводится на основе проведенной антибиотикограммы выявленного возбудителя.
Нередко используются лекарства из группы фторхинолона, такие как левофлоксацин или ципрофлоксацин. Необходимую дозировку и длительность лечения определяет только врач. Ни в коем случае не занимайтесь самолечением, так как оно может стать причиной устойчивости микроорганизма к антибиотикам.
Рассмотрим популярные антибактериальные препараты, назначаемые при данной проблеме:
-
Монурал. Выпускается в виде бесцветного гранулированного порошка, принимать который нужно после растворения водой.
Эффект обуславливается наличием производных фосфоновой кислоты. Это средство относится к антибиотикам широкого спектра действия, при надобности оно может назначаться беременным.
Обычно рекомендуется употреблять 3 грамма раз в сутки. Если инфицирование серьезное, препарат может комбинироваться с другими антибиотиками.
-
Супракс. Выпускается в виде капсул. Основное активное вещество – Цификсим. Используется при ряде инфекций, в частности, при кишечной палочке. Часто назначается вместе с Канефроном, одновременно защищающим мочевыводящие пути от попадания инфекций в них Это весьма сильный и агрессивный антибиотик.
-
Фосмицин. Тоже относится к антибактериальным препаратам широкого спектра действия и представляет собой абсолютный аналог Монурала. Из противопоказаний – беременность, возраст младше 12 лет.
Однако если поражение серьезное, проявляются симптомы воспаления и существует риск внутриутробного поражения, это средство может быть назначено и беременной при тщательном контроле специалиста.
Также используются медикаменты, направленные на нормализацию микрофлоры влагалища. Это могут быть вагинальные пробиотики, которые содержат большое количество лактобактерий.
Предпочтительны составы, которые также содержат особый компонент, способствующий восстановлению эпителия. Хорошие результаты дает использование вагинальных таблеток под названием Гинофлор.
Для восстановления микрофлоры могут использоваться такие препараты, как Экофомин и Вагилак. Для перорального употребления могут быть показаны такие средства, как, например, Нормофлорин.
При наличии кишечной палочки в мазке иногда можно обойтись местным лечением. Оно предполагает регулярную и правильную гигиену наружных половых органов.
Иногда врачи советуют использовать различные травяные отвары вместо фармацевтических средств, например, отвар ромашки.
Терапия может предполагать лечебные спринцевания.
Часто рекомендуется вводить влагалищные свечи, обладающие антисептическими свойствами. Используются свечи с нистатином. Можно получить рекомендацию вводить во влагалище раствор буры 20%.
Из вагинальных свечей могут назначаться Лактобактерин или Бифидумбактерин. В некоторых случаях требуются сеансы ультрафиолетового облучения области половых органов.
Допустимы ли народные средства
Иногда народные средства действительно помогают. Однако перед их применением стоит проконсультироваться со специалистом, чтобы не навредить себе. В народе популярны такие методы:
-
Топинамбур. Несколько плодов топинамбура нужно тщательно промыть, очистить от кожуры. Варить до готовности, затем слить появившийся бульон. Плоды нарежьте на кусочки и залейте кефиром либо сметаной (подойдет любой кисломолочный продукт).
Полученный бульон тоже можно выпить, добавив небольшое количество сметаны и соли. Употреблять готовое блюдо нужно раз в день пока симптомы проблемы не исчезнут. Учтите, что эта мера может использоваться в комплексной терапии, но сугубо она не поможет справиться с заражением.
-
Кефирные примочки. Полезная кисломолочная среда действует на кишечную палочку губительно, поэтому часто рекомендуется употреблять кефир, натуральный йогурт, сметану.
Также можно делать примочки с кефиром. Возьмите стерильный бинт либо вату, качественно смочите их в кисломолочном продукте.
Компресс положите в белье и наденьте его. Полежите так 10 минут, затем хорошо промойте половые органы чистой водой. Повторять в течение недели.
-
Ромашка или календула для обмывания. Эта мера не поможет устранить сам микроорганизм, но сможет устранить симптомы поражения и смыть со слизистой и половых органов погибшие организмы.
Возьмите по 20 грамм трав, залейте их кипятком. Емкость хорошо накройте крышкой и дайте ей остыть. Затем хорошо процедите гущу и применяйте отвар для обмываний. Будет достаточно 7-10 процедур.
Нужно ли лечить мужа
Многих интересует вопрос о том, требуется ли лечение партнеру при обнаружении у женщины в мазке кишечной палочки.
Данный микроорганизм не относится к инфекциям, передающимся половым путем, поэтому при отсутствии других инфекций обследование и лечение мужчине не требуется.
Уровень опасности при беременности
Вопрос об обнаружении микроорганизма в мазке у беременных женщин стоит рассмотреть отдельно. В это время организм будущей мамы и ее иммунитет ослаблен, потому вероятность появления различных инфекций очень высока.
Палочка может проникнуть через плаценту и инфицировать ребенка, что может спровоцировать у него менингит.
Также малыш может заразиться, проходя через родовые пути.
Кишечная палочка может стать причиной вагиноза, который в свою очередь может вызвать преждевременные роды. С антибиотиками беременным также нужно быть осторожными. Ни в коем случае не принимайте никакие препараты без разрешения специалиста.
Нужно как можно раньше отправиться к врачу – он поможет подобрать медикаменты, которые будут безопасными для развития плода, и в то же время смогут нормализовать микрофлору.
А вообще лучше сдать мазок для обследования на этапе планирования беременности. Это сохранит здоровье будущего ребенка и спокойствие мамы.
Меры профилактики
Простые меры профилактики помогут предупредить попадание кишечной палочки во влагалище:
-
Подмывайтесь не реже двух раз в день.
-
Меняйте нижнее белье каждый день.
-
Носите правильное нижнее белье, старайтесь отказаться от стрингов и выбирать трусики исключительно из натуральных материалов.
-
Используйте средства защиты при интимном контакте, внимательно относитесь к выбору половых партнеров.
Кишечная палочка может спровоцировать ряд проблем. Но даже если ее обнаружили, не нужно паниковать. Главное – своевременно отправиться к врачу и начать лечение, избегая сомнительной самодеятельности.
Когда Escherichia Coli может причинить вред?
Почему у одних мужчин наличие кишечной палочки в уретре бессимптомно, а у других она вызывает различные заболевания? При попадании E.Coli в мочеиспускательный канал возможны несколько вариантов ее дальнейшего развития:
- Временное носительство – бактерия «проживает» в мочеполовых путях некоторое время и элиминируется защитными силами организма.
- Постоянное бессимптомное носительство: бактерия персистирует в мочеполовых путях, но ее рост сдерживается теми же защитными факторами.
- Интенсивное размножение и развитие заболевания.
Проникновение подобной болезнетворной флоры непосредственно в органы человека, возможно приведет к развитию очень тяжелых патологий. Инфекция может стать началом перитонита.
Кишечную палочку часто обнаруживают в человеческом организме. Но, не каждый ее штамм опасен для человеческого организма. Некоторые виды этого бактериального микроорганизма, даже полезны. Они способствуют нормальному функционированию кишечника.
Экосистема женского урогенитального тракта
Лейкоциты в мазке, взятом в гинекологии хоть на флору, хоть на цитологию, не единственные клетки, присутствующие в препарате. Кроме того, они выступают лишь как следствие или реакция на происходящие в экосистеме события (колебания гормонального фона, воспаление). Например, их повышение в различные фазы цикла обусловлено гормональным влиянием, поэтому при заборе материала в бланке направления указывается дата последних месячных.
Диагностическим критерием воспалительного процесса считают не только большое количество Le, «сбежавшееся» на место «военных действий», но и состояние их ядер. Когда лейкоциты вступают в реакцию, они пытаются поглотить «неприятеля», фагоцитируют, но сами при этом начинают разрушаться. Разрушенные клетки называют нейтрофильными лейкоцитами, однако в расшифровке анализа такое явление не указывается.
Экосистема женских половых органов включает микроорганизмы, занимающие определенные ниши, которыми являются: эпителий влагалища, шейки матки, цервикального канала, богатого эндоцервикальными железами. Эти анатомические образования обеспечивают условия для жизнедеятельности тех или иных микроорганизмов.
Кроме этого, равновесие в экосистеме способны нарушить различные факторы, негативно влияющие на организм женщины (как внутренние, так и наружные), которые приводят к тому, что микробы, живущие в небольшом количестве, начинают вытеснять естественных обитателей, представляющих палочковую флору, и занимать господствующее положение.
Характеристика патологии человека
Если бактерия покидает свою среду обитания, даже нормальная непатогенная форма может вызвать серьезные расстройства. Наличие её в мазке из влагалища свидетельствует о том, что здоровая микробиота нарушается, и в результате возникает воспаление. Оно распространяется на матку и яичники, входит в уретру, мочевой пузырь, урогенитальный тракт и близлежащие органы.
Для диагностики инфекции, вызванной данными микроорганизмами, можно использовать обычный мазок из слизистой влагалища, поскольку бактерии часто выявляются при исследовании вагинальной флоры.
При положительном ответе на тест можно предположить, что именно кишечная палочка вызывала вагинит, цервицит, эндометрит или другое воспалительное расстройство органов мочеполовой системы.
Обнаружить E. coli можно не только во влагалищном содержимом, но и в мазке из уретры. Инфекция часто распространяется из кишечника ввиду анатомических особенностей строения половых органов у женщин.
Это создаёт благоприятные условия для перехода микроорганизмов из прямой кишки к органам промежности. Женщины чаще страдают от цистита, ввиду способности микроба к восходящему продвижению.
Анализ проводится для выявления инфекции. С Целью диагностики заболевания материал для исследования можно брать из слизистой рта и зева, уретры у мальчиков и влагалища у девочек. Для выявления расстройства желудочно-кишечной системы, вызванного E. coli проводят анализ стула.
Если есть подозрение, тестируют даже водянистый кал без наличия крови, что не свойственно для этих патогенов. Обычные культуры стула, как правило, проверяют на наличие бактерий вида Salmonella, Shigella и Campylobacter.
Поскольку кишечная палочка является частью нормальной фекальной флоры, лаборатории делают специальный анализ для обнаружения патогенной E coli подтипа 0157: H7.
Для точной диагностики инфекции мочевыводящих путей у ребенка требуется надлежащим образом собранный образец мочи, который должен быть чистым и в достаточном объеме. В противном случае необходима катетеризация или аспирация содержимого мочевого пузыря.
Симптомы инфекции могут быть незначительными и неспецифическими у детей грудного, раннего и даже старшего возраста, похожими на проявления распространенных вирусных заболеваний, что приводит к неправильной диагностике и лечению.
У новорожденных и младенцев возможны следующие симптомы:
- вялость;
- гипотермия (понижение температуры тела);
- диарея и/или рвота;
- желтуха;
- лихорадка;
- плохое питание;
- приступы удушья и остановки дыхания;
- раздражительность или суетливость.
Лечение оказывает благоприятное действие. Оно направлено на восполнение потерь жидкости и электролитов. Антибиотикотерапия должна применяться после того, когда будут получены результаты исследования мазков.
Для начала предлагаем вашему вниманию таблицу, в которой отображены показатели так называемой первой степени чистоты. В ней нет упоминаний уретры (хотя материал забирается и оттуда), так как мы говорим о гинекологических заболеваниях. Воспалительный же процесс в мочеиспускательном канале лечит уролог.
Эпителий — количество эпителиальных клеток не считают, так как это не имеет диагностической ценности. Но слишком скудное количество эпителия говорит об атрофическом типе мазка — бывает у женщин в период менопаузы.
Лейкоциты — считаются в «поле зрения»:
- не более 10 — небольшое количество;
- 10-15 — умеренное количество;
- 30-50 — большое количество, женщина замечает патологические симптомы, а врач при осмотре диагностирует воспалительный процесс во влагалище и (или) на шейке матки.
Слизь (тяжи слизи) — в норме должна присутствовать, но большое ее количество бывает при воспалении. В уретре слизи быть не должно.
Палочковая флора или гр лактоморфотипы — норма, это защита влагалища от микробов.
Трихомонад, гонококков и ключевых клеток у здоровой женщины в шейке матки и во влагалище быть не должно. Кандиды в норме также отсутствуют. По крайней мере, в значимом количестве, которое выявляется при анализе на флору.
Годность мазка не большая. Но если женщина поступает в стационар, то у нее прямо там, при первичном осмотре на кресле, берут свежий.
Обычно результаты действительны 7-14 дней. Поэтому, если вам нужно его сдать перед операцией, сделайте это дня за 3 до поступления в больницу. Последним из назначенных анализов.
Материал из уретры мужчины при норме не отличается изобилием. Единичные лейкоциты, переходный эпителий в мазке, единичные палочки – вот и все, что может предоставить нам здоровый мужчина. Появление большого количества лейкоцитов в мазке сильного пола, как правило, сопровождается присутствием виновников воспаления (гонококков, трихомонад, дрожжеподобных грибков рода Candida и др), которое лечат, а затем берут анализ вновь, чтобы убедиться в успехе принятых мер.
Что касается женщин, то повышенное количество лейкоцитов наблюдается перед месячными и считается абсолютно естественным явлением. К тому же, само повышенное содержание (норма – до 30 клеток в поле зрения) к достоверным показателям не относится, свидетельством нормы лейкоцитов считается отсутствие морфологических признаков этих клеток.
Они – «спокойны», не разрушены (ядра сохранены), признаки фагоцитоза отсутствуют. Кроме этого, иной раз причиной заблуждения врача-диагноста может стать неправильно взятый материал. Примером является «густой» мазок, который практически не просматривается ввиду того, что все поле усеяно скоплениями накладывающихся друг на друга клеток (и лейкоцитов в том числе). Не рискуя ошибиться, в подобных случаях женщине предлагают сдать анализ повторно.
Сложность постановки диагноза в том, что симптоматика патологии присуща и другим более частым заболеваниям. К тому же через 2-3 дня все признаки болезни могут исчезнуть.
Основными симптомами заражения вредоносными подвидами кишечной палочки считают:
- постоянную диарею;
- тошноту и рвоту;
- гипертермия;
- снижение аппетита;
- общую слабость и быструю утомляемость.
При наличии патогенных штаммов кишечной палочки в мазке у женщин лечение должно происходить в кратчайшие сроки, поскольку патогенная среда во влагалище приводит к развитию воспалений и появлению различных заболеваний половой системы: вагинита, кольпита, эндометрита, воспаления яичников.
Нередко высокое содержание гемолизирующей бактерии приводит к пиелонефриту у беременных женщин.
Опасность наличия вредоносной бактерии в микрофлоре влагалища кроется в возможности развития многих серьезных болезней, которые со временем могут перейти в хроническую форму и привести к бесплодию.
Заболевания
При попадании в определённые органы, вызывает различные инфекционные заболевания.
- Если обнаружена в кале, значит, попала из кишечника.
- В урине – патология мочевой системы.
- В мазке с уретры — воспаление яичка или его придатков.
- Провоцирует простатит.
Чтобы не заразиться надо:
- Соблюдать чистоту паховой области.
- Избегать незащищенного коитуса.
- После секса принимать душ.
- Носить аккуратную, комфортную одежду.
Чем лечить недуг – эффективные свечи
Чаще всего для локальной борьбы с инфекцией используют антисептики и дезинфицирующие средства. Самым популярным представителем, который назначают гинекологи, является бетадин, в виде вагинальных свеч.
Он блокирует развитие микроорганизмов и вызывает их гибель. Обладает широким спектром антимикробного действия против бактерий (включая E. coli, Staphylococcus aureus), грибов, вирусов, простейших.
Рекомендуется увлажнять свечи водой и вставлять глубоко во влагалище на ночь перед сном. В случае острого вагинита следует использовать 1 суппозиторий, 1-2 раза в день в течение недели.
В случае хронического процесса, курс лечения составляет около половины месяца, при необходимости и дольше. Так как вылечить патологию за неделю не получится, не следует прекращать использование суппозиториев во время менструации.
Норма в гинекологическом мазке
Микроскопические существа, обитающие в половых путях женщины, отличается многообразием, однако нормы все-таки существуют, хотя порой границы их определить весьма сложно, но мы все же попытаемся это сделать. Таким образом, в мазке, взятом в гинекологии можно обнаружить:
- Лейкоциты, норма которых в уретре составляет до 10 клеток в поле зрения, в шейке матки и ее канале – до 30 клеток. При беременности эти показатели меняются в сторону увеличения;
- Вид эпителия в мазке зависит от места забора материала: уретра шейка, влагалище выстланы многослойным плоским эпителием (МПЭ), который мы получим в препарате. Мазок из цервикального канала будет представлен цилиндрическим (призматическим) эпителием. Количество клеток меняется в разные фазы цикла, в целом же, принято считать, что при норме их содержание не должно превышать 10 единиц. Однако все это весьма условно, поскольку для точной диагностики необходимо учитывать морфологические изменения клеточных структур (ядро, цитоплазма, наличие «голых ядер»), то есть, проводить цитологический анализ;
- Слизь в препарате считается обязательным, но умеренным, компонентом, ведь железы цервикального канала и влагалища ее выделяют. Интересно выглядит слизь в овуляторную фазу менструального цикла, она кристаллизуется и образует узоры, похожие на листья растения, которые называют «симптомом папоротника» (цитология);
- Нормальный мазок, как правило, представлен палочковой флорой (лактобациллы) и единичными кокками.
Кроме лактобацилл – основных представителей нормальной микрофлоры половых путей, на которых возложена важная функция «самоочищения влагалищной среды», в мазке можно встретить в небольших количествах и другие, условно-патогенные, микроорганизмы:
- Гарднерелла, которая относится к условно-патогенной флоре и в норме, как правило, «сидит тихо», может при изменении рН очень быстро активизироваться. Ее часто сопровождает мобилункус, проявляющий свою активность после гарднереллы, когда она захватит нишу лактобацилл, размножится и вытеснит последних. При таких обстоятельствах палочки покидают свои «владения», флора меняется, что проявляется значительным увеличение кокков в мазке. Они совместно с гарднереллой и мобилункусом образуют обильную коккобациллярную флору, покрывающую клетки плоского эпителия, и носят название «бактериального песка». Такие интересные клетки МПЭ именуют «ключевыми клетками» и считают диагностическим признаком бактериального вагиноза;
ключевые клетки, облепленные бактериями (справа) и здоровые клетки эпителия (слева)
Все эти представители микрофлоры могут жить, никому не мешая, или вызывать воспаление при определенных условиях. Кстати, даже лактобациллы в избыточном количестве и в обильной бактериальной флоре способны провоцировать воспалительный процесс – лактобациллез, проявляющийся зудом, жжением, выделениями. Болезнь, конечно, не смертельная, но очень мучительная.
Coli обычно обнаруживается в небольшом количестве в микрофлоре влагалища. Это норма! Мазок может показывать множество палочковидных бактерий, но он не способен подтвердить окончательный диагноз. Для этого необходимо выращивать культуру бактерий.
Кишечную палочку часто обнаруживают среди женщин, у которых нет жалоб и симптомов расстройства. Наличие инфекции мочевыводящих путей ещё не означает, что у вас есть E.Coli.
Палочка может попасть во влагалище из прямой кишки или во время полового акта. Обычно заболевание не лечат при отсутствии у женщины симптомов вагинальной инфекции, даже если результаты мазка положительны.
Кишечная палочка и беременность
Бактерии при беременности в организм попадают после полового акта без презерватива. Анализ мазка из влагалища является основной диагностической процедурой. При сборе анализов палочка может попасть в мочу, однако обнаружение бактерий не значит, что женщина болеет. При наличии escherichia coli в посеве на флору у женщины исследуются слизистые выделения из влагалища.
У большого количества женщин кишечная палочка появляется в моче при беременности. Это связано с застойными процессами, происходящими в малом тазу в связи с ростом плода и его давлением на окружающие органы. Также для беременных характерно наличие бессимптомной бактериурии.
Данные состояния требуют обязательного лечения, поскольку кишечная палочка при беременности может стать причиной инфицирования плода в утробе матери, развития воспалительного процесса, заражения бактерий при родах и даже гибели младенца и послеродовых осложнений.
Многие женщины боятся пить антибиотики во время беременности, не осознавая, что риск инфекции гораздо выше риска получить осложнения от лекарственных препаратов. К тому же огромное количество противомикробных и антибактериальных средств разрешены во время вынашивания ребенка и грудного вскармливания.
Какие антибиотики помогают от кишечной палочки? Не смотря на то, что чувствительность к возбудителю заболевания у каждого индивидуальна и «волшебной таблетки», которая поможет всем, не бывает, существует ряд антибиотиков широкого спектра действия, принимаемых для лечения заболеваний, вызванных кишечной палочкой.
В первую очередь это антибиотики пенициллинового ряда (Ампициллин, Амоксиклав), фторхинолоны (Левофлоксацин, Ципрофлоксацин), цефалоспорины (Цефтриаксон, Цефепим), фосфомоцин (Монурал), джозамицин (Вильпрафен), доксициклин (Юнидокс) и др. Дозировка и курс лечения антибактериальными средствами назначается врачом индивидуально в зависимости от вида и формы заболевания, наличия противопоказаний и прочих факторов.
Обычно курс лечения составляет 7-10 дней. Бросать курс антибиотиков, даже если вам стало лучше на 2-3 день, категорически нельзя. Инфекция приобретает резистентность к полученному лекарству, и в следующий раз препарат из данной группы может уже не помочь. Во избежание развития кандидоза и появления дисбактериоза кишечника на время лечения антибиотиками необходимо употреблять капсулы Энтерол.
Помимо антибиотиков женщинам также назначаются вагинальные свечи от кишечной палочки, поскольку основная концентрация бактерии сосредоточена во влагалище, и именно оттуда она забрасывается в уретру, мочевой пузырь, матку и т.д. Наиболее популярные свечи от воспаления, вызванного кишечной палочкой: Гексикон, Полижинакс, Макмирор комплекс, Тержинан, Флуомизин, Бетадин и др.
Следующим этапом после устранения инфекции обязательно является восстановление флоры кишечника и влагалища. Для этого необходимо на протяжении месяца принимать препараты с содержанием лакто и бифидобактерий, например, Нормофлорины, Бифиформ, Хилак-Форте, а также ставить во влагалище свечи с молочной кислотой или лактобактериями: Ацилакт, Лактонорм, Лактожиналь, Фемилекс, Вагилак и др.
Многие пациентки пропускают данный этап, экономя деньги или не желая тратить на лечение большое количество времени, но, увы, без восстановительных процедур бактерия может очень быстро вернуться, особенно после ослабленного лечением иммунитета. При эндометрите и воспалении придатков дополнительно назначаются свечи, поднимающие местный иммунитет: Галавит, Генферон, Полиоксидоний.
Во избежание рецидивов цистита и пиелонефрита, вызванного кишечной палочкой, рекомендуется в течение года предпринимать профилактические меры. Каждые 3 месяца пропивать курс гомеопатических препаратов наподобие Канефрона, Цистона, Фитолизина, Монуреля, Д-маннозы. Тем, у кого процесс принял хроническую стадию, необходимо проконсультироваться насчет применения препарата Уро-Ваксом, курс лечения которым составляет не менее 3 месяцев.
Уро-Ваксом помогает поднять иммунитет мочеполовой системы и способствует снижению количества заболевания циститом. Также хроникам советуют проводить инстилляции (вливания лекарственных средств в мочевой пузырь) антибактериальными препаратами или препаратами, восстанавливающими поврежденную слизистую наподобие Уро-Гиала.
При устойчивости кишечной палочки к антибактериальным средствам возможно лечение бактериофагами, если к ним чувствительность у пациентки имеется. Бактериофаги – более щадящие препараты, не нарушающие биоценоз урогенитального тракта и убивающие только непосредственно определенную инфекцию.
Народными методами кишечная палочка не лечится. Единственное, что можно посоветовать при циститах — это пить как можно больше воды, а также стакан клюквенного или брусничного морса на ночь. Эти ягоды препятствуют размножению и прикреплению кишечной палочки к стенкам мочевого пузыря, тем самым защищая его от вредного воздействия бактерии. Также при цистите полезно пить аптечные травяные сборы: Фитонефрол, Ромашка, Ортосифон и пр.
Как видно из выше перечисленного, лечение кишечной палочки в мазке или моче, особенно в хронической стадии, процесс довольно длительный и дорогостоящий. К сожалению, рецидивы случаются довольно часто, поскольку условно-патогенные бактерии очень живучие и приставучие, поэтому профилактика и укрепление иммунитета – наши лучшие друзья.
Профилактика попадания кишечной палочки во влагалище
Для того чтобы не заразиться вредоносными палочками, необходимо улучшить санитарные условия (чистые продукты, обеззараженная вода, качественное мыло для рук). Детям стоит тщательнее мыть руки и продукты, из которых будут приготовлены блюда. Рекомендуется использовать влажные салфетки и избавиться от антибактериального мыла: оно снижает иммунитет, убивая полезные микробы. Старайтесь чаще менять полотенца, халаты, часто мыть посуду.
От того, обнаружена ли кишечная палочка в мазке вовремя и как скоро был поставлен правильный диагноз, часто зависит исход заболевания и скорость полного излечивания.
Обычно врач при получении положительного результата анализа назначает антибиотикотерапию.
Перед приемом препаратов этой категории следует сдать анализы на резистентность бактерии к определенным видам антибиотиков.
Нормальной средой обитания кишечной палочки является кишечник. Находясь именно здесь, Эшерихия колли в полной мере выполняет свои положительные функции:
-
- Э. колли является антагонистом (непримиримым противником) по отношению к возбудителям кишечных инфекций (шигеллам, сальмонеллам, гнилостным микробам).
- Активно участвует в образовании местного иммунитета.
- Помогает в синтезе витаминов группы В, К, фолиевой кислоты, никотиновой кислоты.
- Принимает участие в водно-солевом и липидном обменных процессах.
- Способствует работе кишечника (улучшает перистальтику и процессы всасывания питательных веществ; помогает расщеплять сложные углеводы).
Как видите, кишечная палочка со всех сторон положительная бактерия. Но нельзя забывать, что Эшерихия колли называют условно-патогенным организмом. Почему?
Дело в том, что в случае снижения иммунитета, либо при попадании в другие места организма, кишечная палочка вызывает заболевания. Представительницы прекрасного пола, маленькие дети, пожилые люди находятся в зоне риска. В случаях с детьми и пожилыми людьми на возникновение заболеваний в большей мере влияет низкий иммунитет. Стоит разобраться, почему женщины так же попадают в эту зону риска.
Как известно, любую болезнь легче предотвратить, чем излечить. Поэтому профилактика – это наше всё! Прежде всего необходимо тщательно соблюдать меры личной гигиены. Регулярное правильное мытьё промежности и половых органов предотвратит попадание кишечной палочки во влагалище. Откажитесь от синтетического, узкого белья. Стринги лучше заменить на трусики-слипы из натуральных тканей. Старайтесь не пользоваться чужими полотенцами, мочалками, бритвами и так далее.
По возможности окажитесь от анального секса. Либо максимально обезопасьте себя: используйте смену презервативов после введения полового члена в анальное отверстие.
Регулярно посещайте своего гинеколога. Кратность посещений должна быть не менее 2 раз в год (один раз в 6 месяцев). Такая частота посещений позволит своевременно обнаружить развитие патологических состояний и принять соответствующие меры.
Не маловажное значение имеет поддержание иммунитета в норме. Для этого рекомендуется правильно питаться (отказаться от жирного, вредного, увеличить в рационе количество фруктов, вводить овощи, рыбу, нежирные сорта мяса и т.д.), чаще бывать на свежем воздухе, заниматься спортом и закаливанием.
Большое значение для поддержания нормальной микрофлоры организма имеет своевременное лечение заболеваний у специалистов. Самолечение, а именно неграмотное использование антибиотиков, приводит к возникновению штаммов бактерий, устойчивых к большинству известных антибиотиков. Возникающие заболевания, вызванные такими супербактериями, очень сложно и долго лечить.
Кишечная палочка была выделена австрийским ученым Эшерихом еще в 1885 году. На сегодняшний день хорошо известны многочисленные разновидности этой бактерии: многие из них безвредны для организма и являются необходимой составляющей микрофлоры кишечника. Помимо того, кишечная палочка синтезирует витамины К, В1, В2, В3, В5.
Однако выделяют более 100 видов этой бактерии, которые являются патогенными и способными спровоцировать развитие серьезных заболеваний либо отравлений. Стоит отметить, что даже бактерии, являющиеся условно-патогенными (к ним относится, например, гемолизирующая кишечная палочка), при попадании из кишечника в иные органы тела человека могут вызвать серьезные осложнения.
Чтобы предупредить инфицирование влагалища патогенной микрофлорой, женщина должна выполнять несколько важных, но элементарных правил. Пункты, которые нужно обязательно соблюдать:
- Проводить туалет наружных половых органов не реже двух раз: утром и перед сном. После подмывания надевать только свежее нижнее белье.
- Отказаться от ежедневных прокладок. Тепло и влага на ней – идеальная среда для размножения бактерий.
- Во время менструации менять прокладки каждые 4 часа, с такой же регулярностью подмываться.
- Гигиенические процедуры проводить рукой. Мочалки, губки, махровые перчатки использовать нельзя.
- При подмывании очищаются только наружные половые органы. Стараться промыть влагалище не следует.
- Для процедуры использовать специальные интимные очищающие средства. Гель для душа, шампунь для этой цели не подходит.
- Гигиеническая процедура должна проводиться не больше минуты. Длительное подмывание разрушает естественную влагалищную микрофлору.
Чтобы не допустить развитие бактериального вагиноза, женщина должна проходить регулярные осмотры у врача. Если возбудитель выявлен на ранних стадиях, и лечение начато вовремя, прогноз на полное выздоровление будет обязательно положительным.
Информация на сайте предоставлена для ознакомления и не является рекомендацией к применению. Обязательна консультация с лечащим врачом.
Как избежать попадания кишечной палочки в половые органы? Подмываться женщинам нужно только спереди назад, желательно принимать душ после каждого акта дефекации, чтобы удалить остатки фекалий с анального отверстия. Ни одна бумага так тщательно не очистит интимные органы, как вода и мыло. При отсутствии возможности воспользоваться душем можно применить влажную туалетную бумагу или влажные салфетки.
Нижнее белье должно быть из натуральных тканей и свободного кроя. От стрингов желательно отказаться вообще. Во время критических дней необходимо как можно чаще менять гигиенические средства и проводить гигиену половых органов. Старайтесь вести упорядоченную половую жизнь и предохраняться барьерными методами контрацепции. До и после интимной близости необходимо помочиться. Так вымываются бактерии из уретры.
Переболевшим циститом или пиелонефритом стоит избегать переохлаждения и принимать профилактические курсы препаратов для предотвращения рецидивов заболевания. Во время анального секса необходимо предохраняться и избегать попадания во влагалище полового члена, побывавшего в анальном отверстии. Время от времени необходимо поддерживать кишечник и пропивать курс пребиотиков. Здоровый кишечник – залог крепкой иммунной системы.
Аднексит: воспаление придатковПричины, симптомы и диагностика аднексита. Лечение и профилактика воспаления придатков.
Противовоспалительные свечи в гинекологииПрименение свечей в гинекологии. Самые эффективные свечи от молочницы, кольпита, баквагиноза.
Бакпосев на флоруКак правильно сдать бакпосев мочи, отделяемого половых путей. Расшифровка результатов бакпосева.